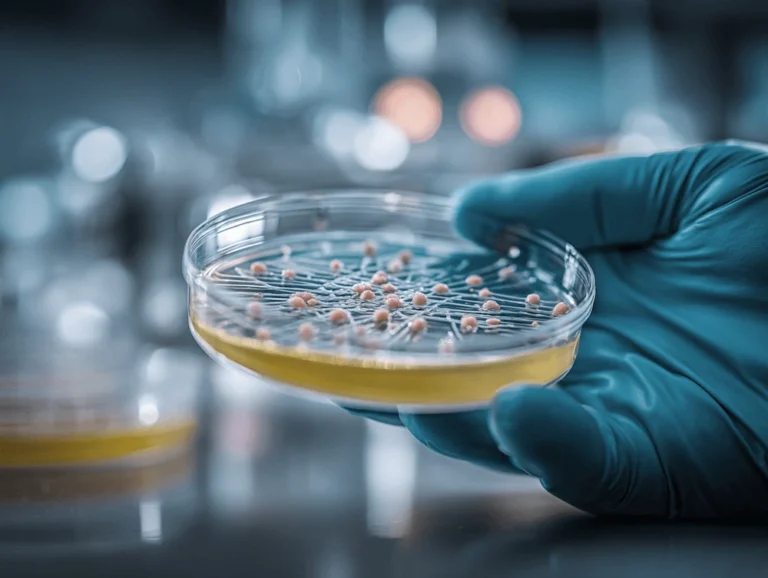
Biologie

Platte LEZ-SAN 65
Santoprene®-Platte, lebensmittelkontaktgeeignet
Material: TPE (PP/EPDM)
Härte: 65 +/-5 Shore A
Eigenschaften: besonders formfest, gute UV- und Lichtbeständigkeit, gutes Kompression-Set, ozonbeständig, recyclingfähig, schweißbar, sehr gute Alterungsbeständigkeit
Konformität: 2003/11/EG, EG 1935/2004 (globale Migration), EU 10/2011 (globale Migration), FDA 21 CFR §177.2600, NSF51, UL gelistet (Nr. QMFZ2.E80017)
Temperaturbereich: -45°C bis +135°C